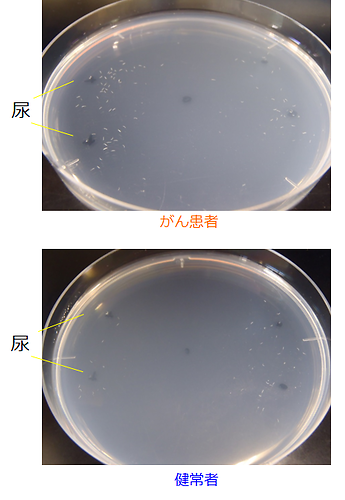
図2

現在、九州大学理学研究院および九州大学病院では、線虫を利用したがん検査の研究は行っておりません。検査の受付等に関して、電話やメールなどで問い合わせいただいてもお答えできませんのでご了承願います。
がんは長年の間、日本人の死因第1位であり、医療費や早期死亡による経済的影響は数兆円(世界では100兆円)にも上ります。がんの対策には早期発見が最も有効であり、手軽に安価に高精度に早期がんを診断できる技術が期待されています。生物科学部門の広津崇亮助教らの研究グループは、線虫が尿によって高精度にがんの有無を識別できることをつきとめました。本研究成果は、米国オンライン科学誌PLOS ONEに掲載されました。
がんによる死亡者数は全世界で年間820万人(2012年)、2030年には1300万人に増加すると言われています(WHO)。我が国でもがんは1981年から死因第1位であり、2人に1人ががんを経験し、3人に1人ががんにより死亡しています。
がんによる死亡を防ぐ最も有効な手段は早期発見・早期治療です。しかし、我が国のがん検診受診率は約30%にとどまっています。その理由としては、「面倒である(医療機関に行く必要がある)」、「費用が高い」、「痛みを伴う」、「診断まで時間がかかる」、「がん種ごとに異なる検査を受ける必要がある」などが挙げられます。そこで、手軽に安価に高精度に全てのがんを早期に診断できる、がんスクリーニング技術の開発が望まれていました。
がん患者には特有の匂いがあることが臨床現場では知られています。このがんの匂いに注目し、犬を用いてがん診断しようという試みがあります。しかし、犬の集中力の問題で1日に5検体程度しか調べられません。そこで研究グループは、線虫C. elegansに着目しました(参考記事:おならと花を間違えない理由 )。線虫は犬と同程度の種類の嗅覚受容体を有する嗅覚の優れた生物であり、匂いに対する走性行動(好きな匂いに寄っていく、嫌いな匂いから逃げる)から反応を容易に調べられます。
がんの匂いは、血液、尿、呼気など様々な物に含まれています。研究グループは、最も採取が簡便な尿に注目しました。まず、がん患者の尿20検体、健常者の尿10検体について線虫の反応を調べたところ、全てのがん患者の尿には誘引行動を、反対に全ての健常者の尿には忌避行動を示すことがわかりました(図1、図2)。また、ステージ1の早期がんにも反応したことから、早期がんを発見できる可能性も示唆されました。

本当に匂いに反応しているのかを確認する為、嗅覚神経を破壊した線虫で実験した所、誘引行動は起こりませんでした。また、線虫の嗅覚神経を調べた結果、がん患者の尿に有意に強く反応している事も確認できました。
線虫の嗅覚を用いたがん診断テスト(n-nose)の精度を調べるために、242検体(がん患者:24、健常者:218)の尿について線虫の反応を調べました。その結果、がん患者をがんと診断できる確率(感度)は95.8%、健常者を健常者と診断できる確率(特異度)は95.0%とどちらも高い確率でした。特に感度は圧倒的で、同じ被験者について同時に検査した他の腫瘍マーカーと比べて極めて高い確率でした(表1)。

従来の腫瘍マーカーが1検体数千円以上かかることを考えると、数百円で行えるn-noseは、コスト面でも優れています。さらに興味深いことに、がん患者24例中5例については、尿が採取された2年前の時点ではがんと診断されませんでしたが、その尿にn-noseを用いると高い確率でがんを発見できています。すなわち、従来のがん検診では見逃されていた早期がんを発見できる可能性を示しています。実際、がん患者24例中12例はステージ0、1の早期がんでしたが、すべて正しく判定できています。
n-noseが実用化されれば、がん検診受診率の飛躍的向上とそれによる早期がん発見率の上昇、がんの死亡者数の激減、医療費の大幅な削減が見込まれ、人類社会全体の変革につながる可能性があります。現在のところ、n-noseは全てのがんを検出できる反面、がん種を特定できない欠点がありますが、研究グループはがん種を特定できる技術の開発に向けて解析を進めています。
より詳しく知りたい方は・・・